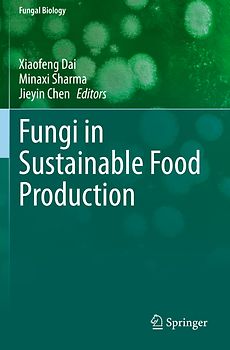
Fungi in Sustainable Food Production

Pheno-phospholipids and Lipo-phenolics

Upcycling of plastic monomers by mixed microbial cultures

Mathematical Models of Cell-Based Morphogenesis
Lieber Geld verdienen als ausgeben?
Verkauf Elektronik und Medien ganz einfach an uns
Versand immer kostenlos und versichert 100 % Löschung deiner Daten Erfahrung und Sicherheit seit 2004
Der Streichpreis bezieht sich auf die unverbindliche Preisempfehlung des Herstellers, den aktuellen durchschnittlichen Neupreis des Produktes bei idealo Deutschland, oder bei Büchern auf den festgelegten Preis für Neuware.